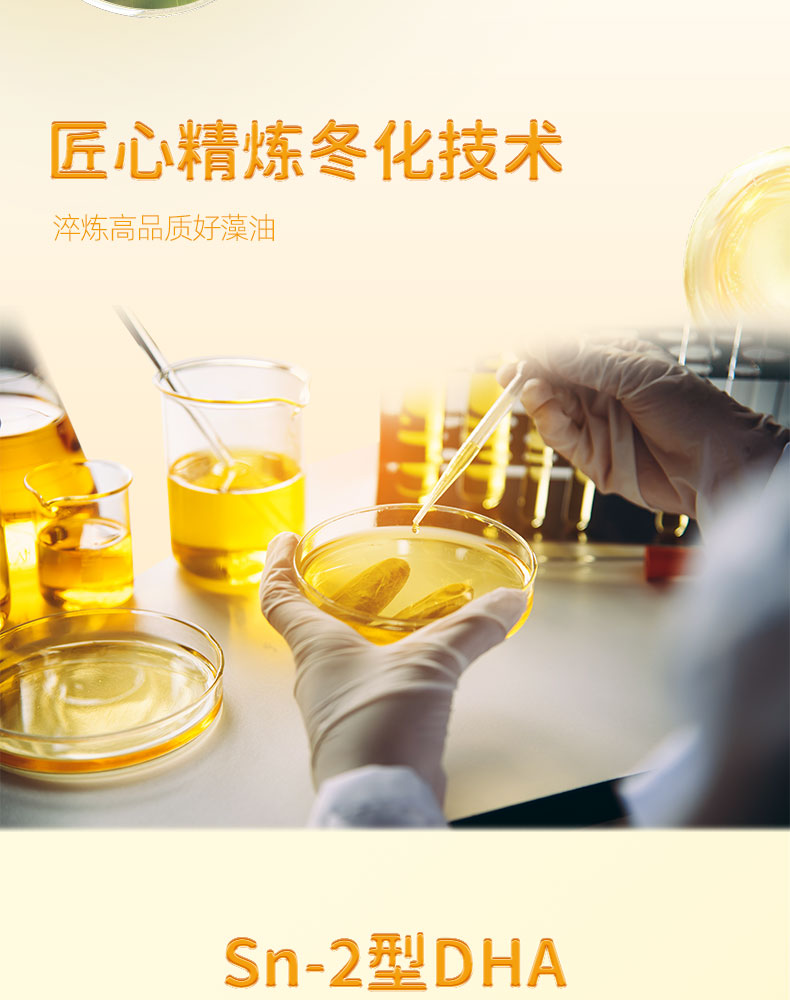

利普乐DHA藻油糖果 | 源自纯净藻油,告别鱼腥味,营养更易吸收-藻油目前无库存 25号正常发货
¥198.00
| 运费: | 免运费 |
| 库存: | 98 件 |
商品详情

- 运通.省心安选
- 扫描二维码,访问我们的微信店铺
















